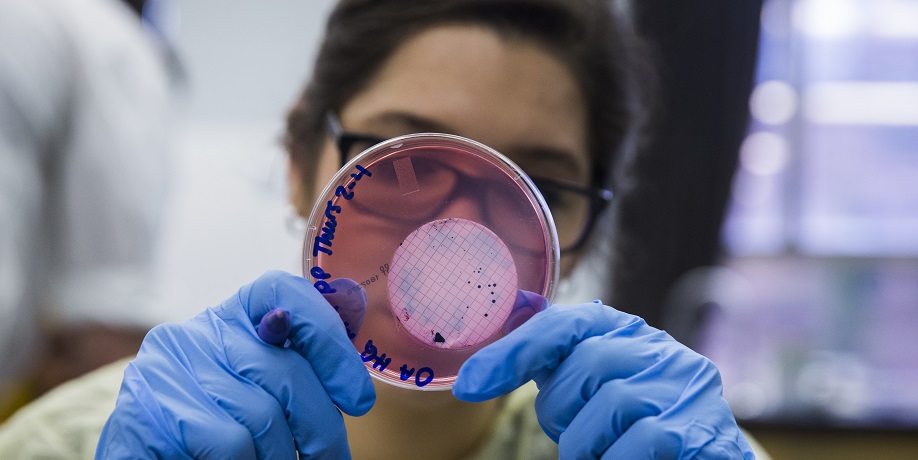

You are now in the main content area
Programs
At the School of Occupational and Public Health, outstanding learning opportunities prepare students to become highly qualified occupational and public health and safety professionals.
At the undergraduate level, we offer a bachelor of applied science (BASc) in Occupational and Public Health via an Occupational Health and Safety option and a Public Health option.
Following completion of a common set of first-year courses, students continue their studies in either Occupational Health and Safety or Public Health.
At the graduate level, we offer a master of science (MSc) in Occupational and Public Health to prepare graduates to address emerging occupational and public challenges. It is the first and only program of its kind in Canada.


